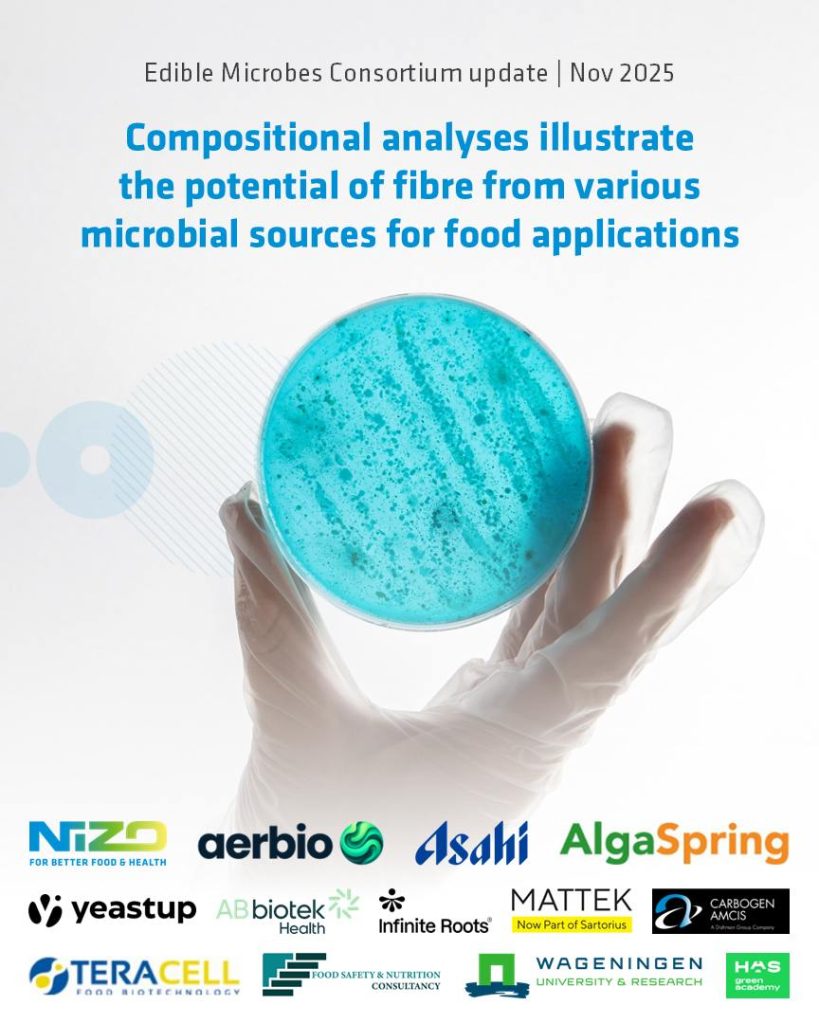
Edible Microbes Consortium update Nov 2025

This consortium focuses on unlocking the full potential of microbial biomass for innovative food products, not just as a protein source, but also for its fibre-rich cell walls. These fibers, like beta-glucans, may offer health benefits, including immune support, while also helping to reduce the global dietary ‘fibre gap’.
BLOG POST TKI Edible Microorganisms – November 2025
The Edible Microbes Consortium was initiated in 2024. In this multi-disciplinary public-private initiative, various industry partners and knowledge institutes team up to explore various sources of microorganisms to tap into market opportunities for food products rich in dietary fibre. On October 2, 2025, the Edible Microbes Consortium met at NIZO (Ede, The Netherlands) for a fruitful project progress meeting. The partners discussed the latest results and shared ideas for the next steps. Over the past year, the team has:

Compositional characterization was performed on a large variety of microbial biomass samples from yeast, bacteria, fungi and microalgae. Based on their fibre content and composition, many samples were found to have interesting properties for food applications. In the coming months, these samples will be studied in more detail.
In addition, the techno-functionality, including water holding capacity and oil holding capacity, of the samples was explored. The next steps will be to perform viscosity and emulsion analyses on the most promising samples.
A comprehensive review around safety considerations for producing edible microorganisms is in progress, focusing on potential contaminants. This work lays a critical foundation for identifying potential risks and performing risk assessments to ensuring development of safe microbial-based food products. In addition, the team introduced a practical roadmap specifically relevant to edible microbes based on the Document ‘Guidance on the scientific requirements for an application for authorisation of a novel food in the context of Regulation (EU) 2015/2283. This is important for ensuring compliance and smooth market entry. Together, these efforts represent a vital step in enabling the safe and sustainable use of microbial resources in the food system, supporting innovation while protecting public health.
Results of the first exploratory consumer study by HAS Green Academy showed that 81% of 300 respondents were to a certain extent open to eating foods containing microorganisms. Within this group, health-conscious consumers were the most willing to try such products. In the coming year, the team will take a closer look at how consumers perceive different types of microorganisms for food applications and develop a mockup product to obtain direct feedback from potential future consumers.
The next step in the project will be to screen for the potential of both crude biomass and purified fibre samples from edible microorganisms to exert effects on human health after oral consumption. This research includes:
We are very excited to seeing the first results from these studies! Moving forward, insights obtained from this project will unlock innovation opportunities to provide safe and healthy food products based on edible microbes towards a resilient, sustainable food system.
This project receives financial support from the Top Sector Agri & Food. Within the Top Sector, the business community, knowledge institutions and government work together on innovations for safe and healthy food for 9 billion people in a resilient world. This consortium is scheduled to run from 2024 to 2027.